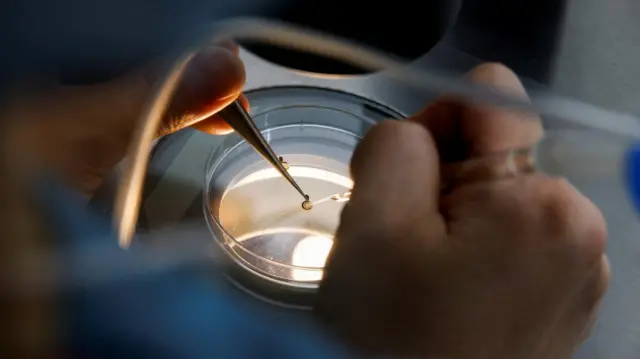
An employee demonstrates the work process before freezing eggs in a Fertility Research lab at Cha Fertility Center in Bundang, South Korea, April 30, 2022.

Як жінки заморожують яйцеклітини і що може піти не так

Автор фото, Getty Images
- Author, Кеті Бішоп
- Role, BBC Worklife
Заморожування яйцеклітин давно перестало бути виключно медичною процедурою. Жінки звертаються до кріоконсервації з різних причин — наприклад, через проблеми зі здоров'ям, або коли не хочуть переривати кар'єру чи прагнуть підготуватися до народження дитини фінансово.
В останні роки репродуктологи фіксують збільшення кількості заморозок — через бажання відкласти материнство до кращих часів. Однак це має свої мінуси, кажуть фахівці.
Кілька років тому Елізабет Кінг, консультантка з питань безпліддя в Лос-Анджелесі, помітила зміни серед своїх пацієнтів. Раніше Кінг переважно консультувала жінок під час лікування безпліддя чи після втрати вагітності, але зараз до неї все частіше звертаються пацієнтки, які ще навіть не планують завагітніти.
"Багато з них мають побоювання щодо свого віку, історії хвороби та часто анекдотичного досвіду чи інформації, яку вони зібрали з різних ЗМІ, - каже Кінг. - Спільним для них є прагнення впевненості та контролю над своїм репродуктивним вибором".
У відповідь на запит зростає ціла індустрія, яка допомагає жінкам оцінити, покращити чи подовжити свою фертильність.
Дані свідчать, що заморожування яйцеклітин, тестування фертильності та консультації перед зачаттям, стають все популярнішими, а деякі компанії навіть пропонують їх своїм працівникам як бонус.
Прогнозують, що до 2025 року глобальний ринок тестів на фертильність становитиме 680 млн доларів проти 472 млн доларів у 2020 році.
Однак не всі рекомендації і послуги можуть бути корисними, попереджають експерти.
End of Підписуйтеся на нас у соцмережах

Автор фото, Getty Images
"Хибне почуття безпеки"
Як дізнатися головне про Україну та світ?
Підписуйтеся на наш канал тут.
Кінець Whatsapp
Жіноча фертильність значною мірою залежить від віку, найактивніший жіночий період триває в середньому до 35 років.
При досягненні критичного віку, коли різко знижуються шанси народження дитини, заморожування яйцеклітини може зберегти опцію завагітніти у майбутньому.
Але чи є цей процес дійсно гарантією на появу дитини?
Кріоконсервація має багато переваг, але також може створювати хибне почуття безпеки, вважає консультантка з фертильності Елізабет Кінг.
У 2017 році британське управління із запліднення та ембріології людини (HFEA) виявило, що з усіх яйцеклітин, розморожених у Британії з 2013 року, лише 15% були запліднені. З них тільки 13% прижилися та закінчилися вагітністю.
Дані американських медиків більш оптимістичні. Вони кажуть, що приживаються близько 39% (тобто дві-чотири клітини з десяти).
При цьому більша частина профілактичних заходів щодо лікування безпліддя орієнтована на жінок. Хоча 40-50% випадків безпліддя пар обумовлене чоловічим фактором - низькою концентрацією чи поганою рухливістю сперматозоїдів.
Це спричинило побоювання, що деякі медичні компанії наживаються на підвищених страхах жінок щодо безпліддя.
"Щоб народити дитину, потрібні двоє, а половина пацієнтів, які потребують допомоги, страждають від безпліддя за чоловічим фактором", — каже Кристина Хікман, директорка й співзасновниця британської клініки репродуктивної медицини Ovom.
Низький рівень надійності
На зачаття впливають безліч факторів, тому деякі експерти вважають, що, приміром, тестування на фертильність, яке зазвичай оцінює лише гормони та резерви яєчників, переоцінене.
Нещодавні дослідження виявили, що багато компаній, які проводять тестування оваріального резерву в домашніх умовах, мають низький коефіцієнт надійності.
Це означає, що люди можуть приймати доленосні рішення щодо свого репродуктивного здоров’я на основі недостатніх даних.
Експерти також стурбовані тим, що репродуктивна індустрія орієнтується передусім на отримання прибутку.
"Деякі послуги, як-от тестування фертильності, можуть бути відносно доступними, тоді як вартість хибного рішення на його основі обійдеться дуже дорого", - каже Кавелль Крісті, директорка Програми гендерної рівності в групі захисту здоров’я Community Catalyst.
Автор фото, Reuters
"Індустрія штучного запліднення – багатомільярдний бізнес, який, на жаль, як і багато інших послуг у сфері охорони здоров'я, часто націлений на прибуток, а не на турботу про пацієнта, - каже вона. - Надмірно високі ціни на такі послуги часто роблять їх недоступними".
Середня вартість циклу заморожування та розморожування яйцеклітин становить від 7 000 до 8 000 фунтів стерлінгів у Британії та від 8 000 до 15 000 доларів у США. Щоб підвищити шанси на успіх, лікарі рекомендують кілька циклів збирання яйцеклітин, що може коштувати додатково від 4 000 до 5 000 фунтів стерлінгів за один раз.
Такі витрати все частіше змушують підприємства пропонувати кріоконсервацію як бонус. Приміром, Apple і Facebook фінансують заморожування яйцеклітин своїх працівниць на суму до 20 000 доларів.
Це означає, що багато репродуктивних послуг є прерогативою лише багатих або тих, хто працює у великих і фінансово успішних корпораціях, каже Кавелль Крісті. А от люди з низькими доходами та мешканці сільських громад, де медичне обслуговування є важкодоступним, часто в це коло не потрапляють.
Агресивний маркетинг
Ще однією проблемою ринку репродуктивних послуг стала агресивна реклама.
Дослідження свідчать, що, приміром, таргетована реклама тестів на фертильність або заморожування яйцеклітин направлена навіть на зовсім молодих жінок – від 20 до 30 років. Вони постійно бачать її на своїх сторінках у соцмережах.
А недавнє опитування користувачок мобільних застосунків для відстеження менструального циклу показало, що більшість з них помітили збільшення реклами, пов'язаної з дітьми чи фертильністю.
Така агресивна реклама може призвести до непотрібних занепокоєнь, кажуть експерти.
"Вона може підживлювати тривоги щодо можливих проблем із зачаттям, особливо, коли грає на страхах, пов'язаних із віковими обмеженнями, - пояснює Кінг".
Вона переконана, що не всім, кому продають ці послуги, вони дійсно потрібні.

Автор фото, Getty Images
Неідеально, але важливо
"Кріоконсервація — відносно нова сфера медицини, яка швидко розвивається. Тому важливо, щоб доступ до неї був справедливим і доступним", - вважає Кавелль Крісті.
На її думку, такі послуги корисні для людей, які хочуть оцінити, покращити чи подовжити свою фертильність, або створити сім'ю, коли і якщо захочуть.
З нею погоджується консультантка з питань безпліддя Елізабет Кінг: "Розуміння, як влаштоване і працює власне тіло, може допомогти в довгостроковій перспективі".
На її думку, фертильна медицина, хоч і має важливі переваги та може запропонувати пізнє, "відкладене" материнство, однак має надавати чітку, збалансовану інформацію без маніпуляцій страхом та невпевненістю.











